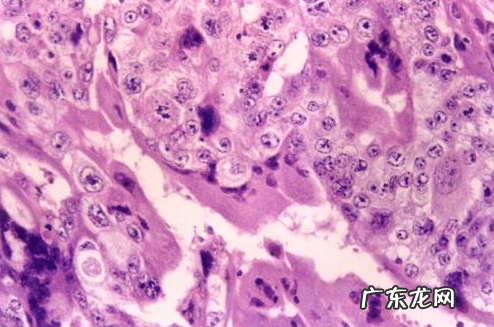
绒毛膜癌是什么意思 绒毛膜癌

去年3月,薛女士突然出现了腹痛、腹胀,随即和老公赶到当地的医院,经过一系列的检查,最后彩超结果显示她的腹部有一个包块,初步诊断是绒毛膜癌,医院医生建议她们去省里的大医院治疗 。

文章插图
薛女士和老公来到了省里的医院求诊,医生听完她的病情后,立马为薛女士接诊,在询问完她的病史后,再看了看她的相关检查结果说道:你这是癌症晚期了,而且可能病情会随时加重,可能会威胁到生命,随即立马安排薛女士入院 。
入院以后,医生仔仔细细地给薛女士做全身检查,想尽办法稳定病情 。医生确认薛女士的病是绒毛膜癌晚期,属于极高危的状态,随时会危及生命 。

文章插图
绒毛膜癌发病率非常低,是妇科疾病中的一种恶性肿瘤,但是它对药物极其敏感,这种肿瘤是有可能治愈的 。不过这种手术很危险,对医院的挑战也非常大,需要医院各科一起讨论,给薛女士定制专门的治疗方案 。
通过和他丈夫以及其他家人的交流,他们都同意了这种专门定制的治疗方案,随即立刻安排薛女士的手术,开始了这场漫长的治疗 。

文章插图
从3月份到12月,长达9个月的治疗,薛女士经历了大大小小十几次化疗 。期间医生为了她的心理健康还给她找了心理医生 。结束了最后一次化疗后,薛女士顺利出院,期间来医院做了几次复查,身体各项指标开始恢复正常,身体也没有什么不适感了,薛女士抗癌成功、重获新生 。
什么是绒毛膜癌

文章插图
绒毛膜癌是一种很少见的恶性肿瘤,特点是滋养细胞异常增殖入侵到了子宫肌层里,造成局部的严重损害,还会转移到身体的其他部位里 。
大部分绒毛膜癌患者都发生在育龄妇女身上,主要的表现为阴道不规则流血、腹痛、假孕等现象,癌细胞转移后会因为转移到的部位不同,从而出现不同的症状 。
关于绒毛膜癌的治疗主要以化疗为主手术、放疗为辅 。由于现代化疗技术的完善,绒毛膜癌患者治愈后的预后也得到了极大改善 。
为什么会患上绒毛膜癌
即便是医疗技术如此先进的今天,对于绒毛膜癌的认识也没有太深入,具体的发病原因至今也没弄清楚,基本都是假设居多 。
文章插图
1、营养不良
根据实验发现,动物如果体内缺乏叶酸的话,会导致胚胎死亡 。所以推测出叶酸可能和细胞肿瘤有关 。
如果食物烹煮过熟,会破坏食物里固有的蛋白质、维生素和叶酸、胡萝卜素等 。
2、病毒学说
研究发现绒癌组织中会分离出一种病毒,叫做 亲绒毛病毒,这种病毒是导致滋养细胞肿瘤的主要原因 。
3、内分泌失调
20岁以下及40岁以上的患者发病率比其他年龄段的女性更高,以为这个年龄段要么是卵巢功能还不完全,要么是已经发生衰退,故会认为滋养细胞肿瘤与内分泌功能有关 。
4、孕卵缺损
20岁以下及40岁以上的患者中葡萄胎发生率也较高,可能与孕卵本身缺陷有关 。
5、种族因素
这种疾病高发于亚洲各个国家,特别是东南亚一带,这可能与种族因素有关 。
- 护理假是什么意思 护理假
- BAT指的是什么意思 bat是什么意思英语
- 九块九到底是什么意思 淘宝九块九的衣服是真的吗
- 淘宝客服干什么工作内容 淘宝客服的工作内容是什么
- 大暑古诗曾几 大暑三候是什么
- 多多进宝补单怎么操作?拼多多补单方式是什么?
- 淘宝双11开团提醒什么意思?双十一抢购技巧是什么?
- 零售通运营专家做什么?零售通是什么?
- 复制快捷键是哪个键 页面复制快捷键是什么
- 鸭掌木风水作用 木鸭子在风水中的作用是什么
特别声明:本站内容均来自网友提供或互联网,仅供参考,请勿用于商业和其他非法用途。如果侵犯了您的权益请与我们联系,我们将在24小时内删除。
